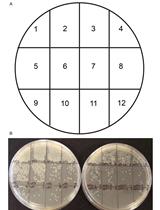
Quantification of Neisseria meningitidis Adherence to Human  Epithelial Cells by Colony Counting

- Protocols
- Articles and Issues
- About
- Become a Reviewer
Past Issue in 2018
Volume: 8, Issue: 3
Biochemistry
FRET-based Stoichiometry Measurements of Protein Complexes in vitro
Cell Biology
Tracking Endocytosis and Intracellular Trafficking of Epitope-tagged Syntaxin 3 by Antibody Feeding in Live, Polarized MDCK Cells
Ex vivo Analysis of Lipolysis in Human Subcutaneous Adipose Tissue Explants
Measurement of Lysosomal Size and Lysosomal Marker Intensities in Adult Caenorhabditis elegans
Analysis of Chromosome Condensation/Decondensation During Mitosis by EdU Incorporation in Nigella damascena L. Seedling Roots
Developmental Biology
How to Catch a Smurf? – Ageing and Beyond…
In vivo Assessment of Intestinal Permeability in Multiple Model Organisms
Preparation of Precisely Oriented Cryosections of Undistorted Drosophila Wing Imaginal Discs for High Resolution Confocal Imaging
Microbiology
Extraction of DNA from Murine Fecal Pellets for Downstream Phylogenetic Microbiota Analysis by Next-generation Sequencing
Quantification of Neisseria meningitidis Adherence to Human Epithelial Cells by Colony Counting
Immunofluorescence Analysis of Human Endocervical Tissue Explants Infected with Neisseria gonorrhoeae
Molecular Biology
Immunoprecipitation of Tri-methylated Capped RNA
Precision Tagging: A Novel Seamless Protein Tagging by Combinational Use of Type II and Type IIS Restriction Endonucleases
Measuring Nucleosome Assembly Activity in vitro with the Nucleosome Assembly and Quantification (NAQ) Assay
Medaka-microinjection with an Upright Microscope
Determination of DNA Damage in the Retina Photoreceptors of Drosophila
Neuroscience
Culture and Nucleofection of Postnatal Day 7 Cortical and Cerebellar Mouse Astroglial Cells
Plant Science
Investigating Localization of Chimeric Transporter Proteins within Chloroplasts of Arabidopsis thaliana
Identification of Insertion Site by RESDA-PCR in Chlamydomonas Mutants Generated by AphVIII Random Insertional Mutagenesis
Radioactive Tracer Feeding Experiments and Product Analysis to Determine the Biosynthetic Capability of Comfrey (Symphytum officinale) Leaves for Pyrrolizidine Alkaloids
Systems Biology
Extraction and Analysis of Pan-metabolome Polar Metabolites by Ultra Performance Liquid Chromatography–Tandem Mass Spectrometry (UPLC-MS/MS)